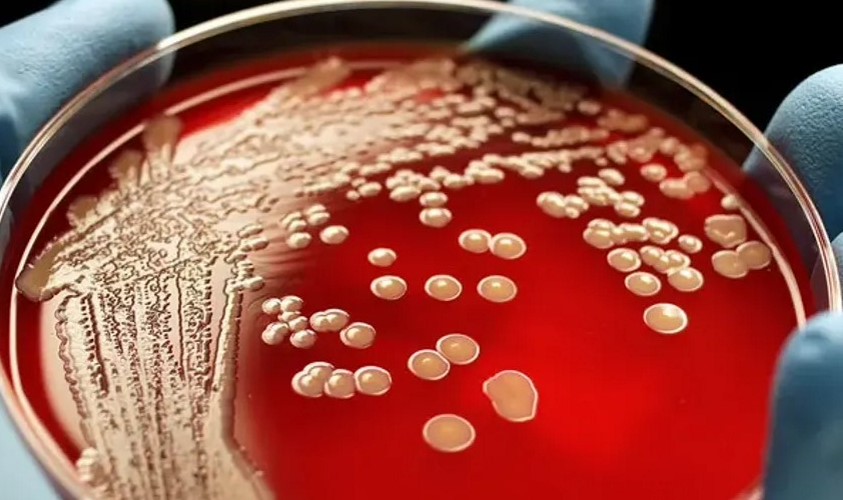
Criou um antibiótico que destrói todas as cepas de estafilococos resistentes

Os cientistas mostraram que a droga destrói efetivamente todas as dez cepas resistentes testadas de Staphylococcus aureus e também possui outras propriedades incomuns. Por exemplo, restaura a sensibilidade das bactérias aos antibióticos já existentes. Estes são resultados muito promissores para superar a ameaça global à saúde humana - a resistência em massa aos antibióticos, que causa a morte de aproximadamente 1 milhão de pessoas anualmente.
A resistência bacteriana aos antibióticos existentes e a falta de novos medicamentos ameaçam a capacidade de tratar eficazmente as infecções bacterianas. Segundo dados de 2019, a resistência aos antibióticos levou a um milhão de mortes no mundo e, segundo especialistas, esses números só vão aumentar. Entre os patógenos mais perigosos conhecidos, Staphylococcus aureus resistente à meticilina (MRSA). Agora, cientistas do Reino Unido apresentaram um composto que destrói a superbactéria MRSA, relata o Science Daily.
A droga experimental AHA-1394 refere-se a poliaminas, compostos naturais encontrados na maioria dos organismos vivos, que, por sua vez, são tóxicos ao MRSA, como mostram estudos recentes. AHA-1394 é uma poliamina modificada que mata cepas resistentes de Staphylococcus aureus com muito mais eficácia do que sua contraparte natural, explicam os autores.
Para matar o patógeno, a concentração de AHA-1394 deve ser 128 vezes menor que a da poliamina natural.
Os cientistas mostraram que o AHA-1394 inibiu o crescimento de todas as dez cepas resistentes testadas, incluindo aquelas resistentes à vancomicina, o antibiótico mais comumente prescrito. Além disso, o AHA-1394 impediu a formação de biofilmes, uma comunidade de microrganismos de difícil tratamento, embora não tenha destruído os biofilmes existentes.
AHA-1394 restaurou a sensibilidade de bactérias multirresistentes a três antibióticos importantes - daptomicina, oxacilina e vancomicina.
Até agora, os cientistas não conseguem explicar por que isso está acontecendo, mas o resultado abre oportunidades incríveis para a “reabilitação” de antibióticos antigos. A pesquisa está em andamento.
Recentemente, outro antibiótico promissor foi isolado de bactérias patogênicas da batata. Os cientistas mostraram que tem um amplo espectro de ação contra fungos.
2022-10-12 21:08:33
Autor: Vitalii Babkin